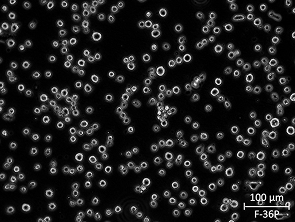
Brightfield micrograph of F-36P, showing adherent and suspension growth.

Inquiring F-36P
We know how valuable your research is to you, but are you wondering what you can expect to pay for quick accurate results every time? Fill out a request in the form below and we’ll get back to you within 24 hours with a quote.
High Viability
To succeed in cell culture
Precision and Reliability
To support a consistent result
Customization Options
Tailed to your research